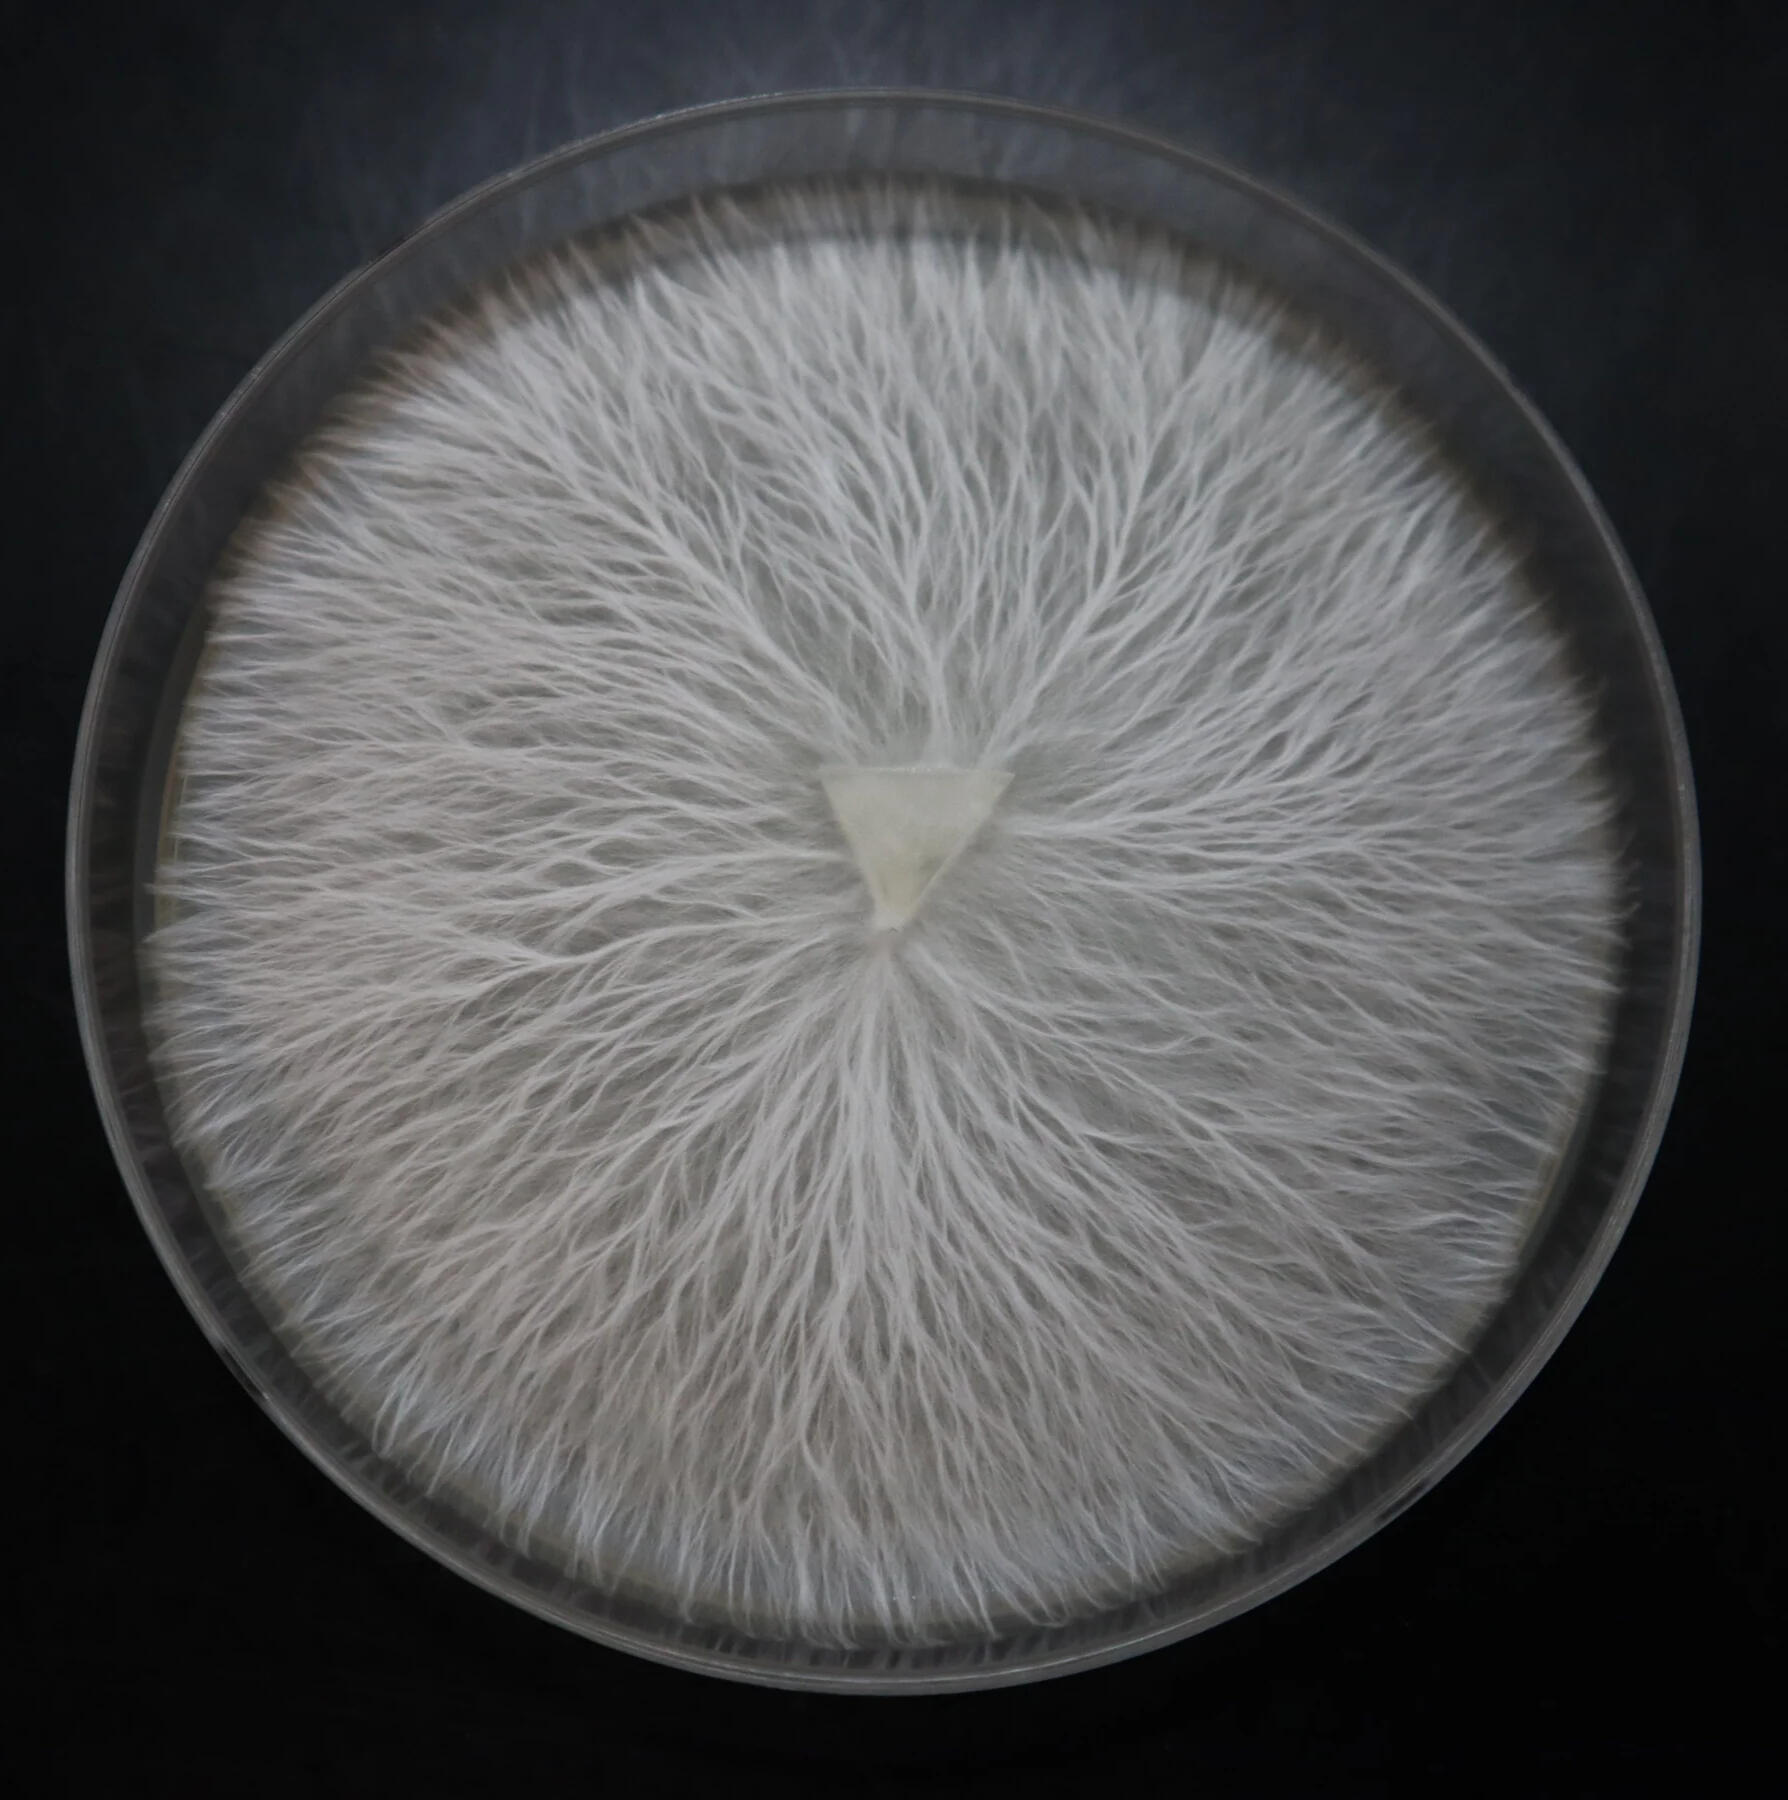
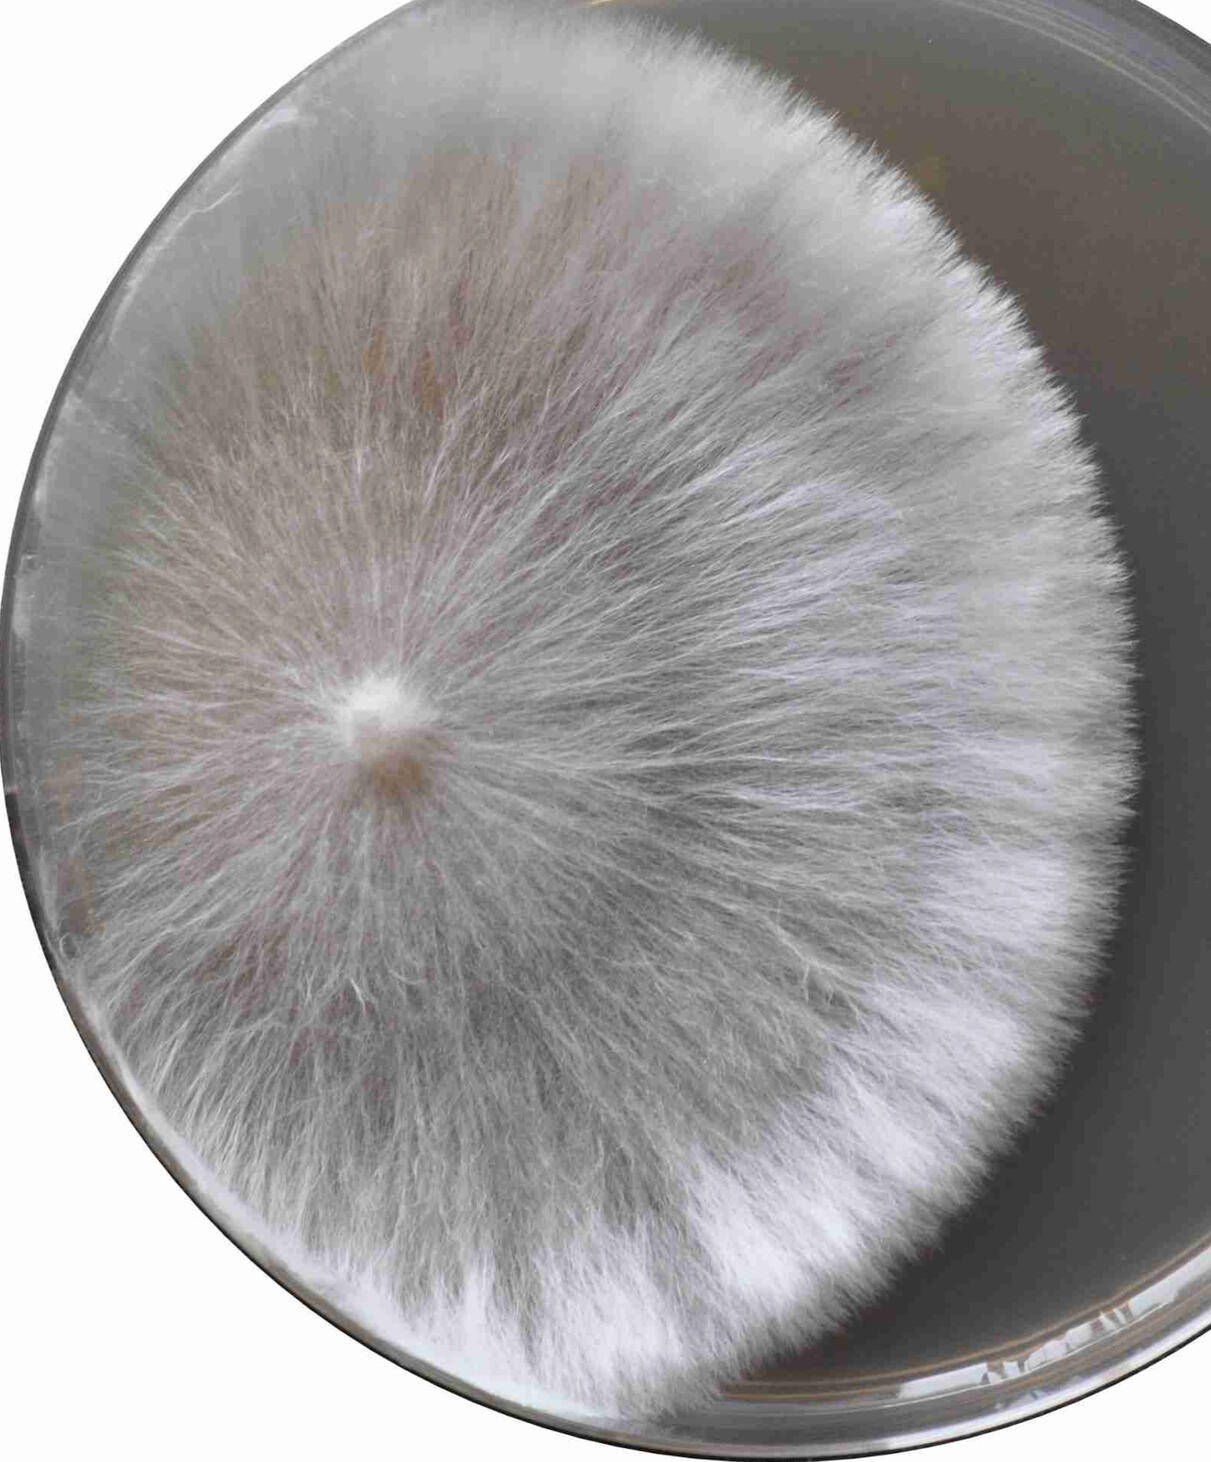
US

the future powered with mycelium
We believe in the symbiosis of human and mycelium in the future, for our planet.
Celium Lab is committed to empowering businesses with high-quality, next-generation mycelium-based materials.Rooted in innovative research and expert craftsmanship, we are committed to materials that are both high-performing and sustainable.

Mycelium - the roots of mushrooms- is the core of our technology. As mycelium grows, each thread-like hypha connects and overlaps with others, creating a strong foundation for our material.Thanks to our patented technology, we’ve developed a mycelium-based material that is both lightweight and durable, offering performance similar to traditional animal-based leather.
Sustainability is at the core of our mission – Our product offers an eco-friendly solution with its 100% biodegradable composition and animal-free production process.By using this product, you are directly supporting efforts to reduce greenhouse gas emissions and help maintain a carbon-zero footprint for a healthier planet.


COME

JOIN
US
Have questions or ready to connect? Reach out to us - we're here to help!
#B-1304, 12, Dongbu-ro 169 beon-gil, Jinju-si, Gyeongsangnam-do, Korea 52818